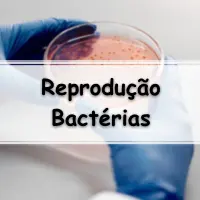
simulado sobre a Reprodução das Bactérias Exercícios com gabarito para passar no enem e vestibular

Reprodução das Bactérias 05 Exercícios com Gabarito
Questão 01. (UFC) Reprodução das Bactérias Exercícios: Analise o texto a seguir:Nas bactérias, o material genético está organizado em uma fita contínua de ________ que fica localizado em uma área chamada de __________. A reprodução das bactérias se dá principalmente por __________, que produz ____________. Assinale a alternativa que completa CORRETAmEnTE o texto:A) cromossomos – … Leia mais…